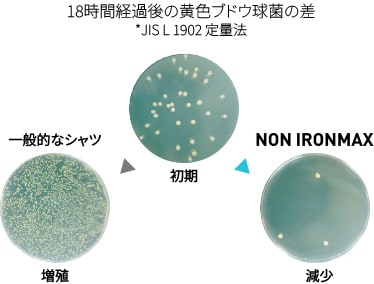
制菌加工

累計販売枚数1,700万枚※
ノンアイロンマックスが選ばれる
6つの理由
6つの理由
※2026年5月末時点
-
1日着てもよれない防シワ性能分子レベルで繊維の結合力を高め強力なノンアイロン性を付与。
-
夜干して翌朝乾く速乾性約2時間半で水分量が0%に!出張先や時間のない日も安心の速乾性。
-
着心地の良さMAX綿100%天然素材で肌にやさしいコットン。繊維が非常に長く地球上の綿花のうち約5%しか生産できない超長綿を採用。
- 超長綿の特徴
- 艶やかで上品な光沢、しなやかな風合いとなめらかな肌触りが魅力です。
-
部屋干しで臭わない制菌加工部屋干し臭の原因となる細菌の増殖を銀イオンの力で制御。常に清潔な状態をキープします。
-
汚れがつかない、落ちやすい防汚加工100回洗濯しても効果はそのまま。安心して長くご愛用いただけます。
-
世界基準の認証取得安全性身体への安全性を証明する「エコテックス®スタンダード100認証」を取得。
肌アレルギーにお悩みの方や
小さいお子様の肌に触れても安全です

-
01
帰宅してもシワが気にならない。
特殊加工の繊維と青山の技術が生んだ長持ちプリーツ加工 -

02
意外と目に付く襟そでの黄ばみ汚れがするっと落ちるのでノータイスタイルに自信が持てます -

03
花粉の季節や洗濯物が乾きにくい冬場など、部屋干しの機会が増えても清潔で気持ちよく -

04
コットン100%なのに、夜に干せば朝に着られる優秀な速乾シャツ、長期出張の強い味方です

-
ジャケットを脱いでもキマル、こだわりの5箇所テープ縫製で360°シワ無しMAX -
艶やかで上品な光沢、しなやかな風合いとなめらかな肌ざわり“綿の宝石”超長綿100%
- 【オンラインストア限定】
- ノンアイロンマックスの日は、
毎月24日! - [24日10:00am~25日9:59amまで]
※すでに1,000円以上割引された商品は対象外となります。


| ブランド |
NON IRONMAX綿100%なのに
|
SUPER EASYIRON動きシゴトに対応
|
SUPER EASYIRONコスパ最強
|
|---|---|---|---|
| 価格 | 6,490円 | 5,390円 | 4,290円 |
| 素材 | 綿100% | ポリエステル60% 綿40% |
ポリエステル70% 綿28% ポリウレタン2% |
| 形態 安定度 |
★★★★★ アイロンがけ不要 |
★★★☆☆ アイロンラクチン |
★★★☆☆ アイロンラクチン |
| ストレッチ | ★★★★★ | ★★★☆☆ | ★★★☆☆ |
| 機能 |
部屋干しでも匂わない |
汗をかいても気にならない |
国際的安全基準エコテックス(R)に |
★★★★★ 294件のレビュー ※
※2024年5月15日時点
-
20代男性
身長176-180cm★★★★★アイロンをかける手間がかからず、何年も継続して購入しています。
-
30代男性
身長176-180cm★★★★★スタンダードな白無地のシャツで間違いない1枚。困ったときはコレで!
-
20代女性
身長161-165cm★★★★★父の日のプレゼントにしました。喜んでもらえてよかったし、私もアイロン作業減るから嬉しい♪
-
40代男性
身長171-175cm★★★★★ノンアイロンマックスの名前に偽りはありません!驚くほどのピンシャキです!古くなったシャツを順番に、このシャツに入れ替えていきます!
-
20代男性
身長176-180cm★★★★★洗濯しても本当にアイロンいらずです。しかもスタイルがよく見えてカッコいいシャツです。これしか買いません。
-
40代女性
身長161-165cm★★★★★仕事の為、体に沿うようなフィット感が気持ちいい。ノンアイロンでいつもきっちりと見えるのが良い。
-
40代女性
身長161-165cm★★★★★かなり着やすいです。透け感もなくとても良い。洗濯後、本当にノーアイロンでも着られます。リピ買いです。
-
50代女性
身長161-165cm★★★★★20代の娘の仕事用に購入しました。アイロンいらずでとっても便利です。
-
50代男性
身長171-175cm★★★★★以前着ていたシャツとは違い、洗濯してもシワが付かないので扱いもたいへん楽です。

算定した商品はこちら
- カーボンフットプリント(CFP)とは
- Carbon Footprint of Product の略語。製品やサービスの原材料調達から廃棄、リサイクルに至るまでのライフサイクル全体を通して排出されるGHGの排出量をCO2排出量に換算し、製品に表示された数値もしくはそれを表示する仕組み。





















